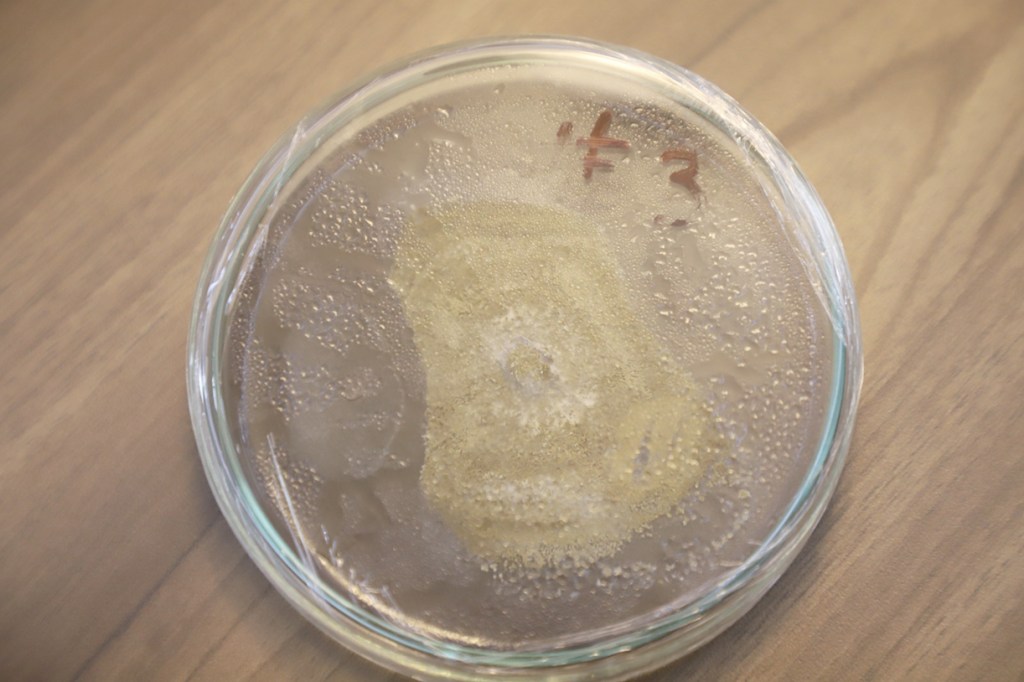

Alcalde, Aldo Ledezma Reyna entrega apoyos económicos por 10 mil pesos a damnificados por lluvias en Rancho San Blas.

La Mtra. Brenda Stephanie Selene Aguilar Zamora Presidenta Honoraria del Sistema Municipal DIF de Cuautitlán también colaboró apoyando a las familias.

Brenda Aguilar apoyando a su esposo Aldo Ledezma en la entrega de apoyos económicos, manifestó que es difícil atender a tantas familias frente a las innumerables necesidades en sus hogares.

Nuevamente se hizo presente de manera inmediata el alcalde de Cuautitlán para entregar despensas a familias afectadas por las intensas lluvias en Rancho San Blas donde les produjo innumerables daños materiales.
Cuautitlán, Méx.- El Presidente Municipal, Aldo Ledezma Reyna, acompañado de su esposa e integrantes de Cabildo hicieron entrega de apoyos por parte del gobierno municipal a las y los vecinos de Rancho San Blas afectados por las inundaciones del pasado mes de Junio.
Los apoyos constan de un sustento económico por la cantidad de 10,000 mil pesos, que se dividirá en dos exhibiciones. Reiterando su compromiso para seguir emprendiendo acciones en apoyo a este fraccionamiento.
Aldo Ledezma, comentó que “seguiremos con las gestiones pertinentes y en coordinación con los tres órdenes de gobierno para solicitar mayores apoyos para cada una de las familias afectadas, en esta ocasión el apoyo es totalmente con presupuesto municipal.
También continuaremos con las medidas y trabajos preventivos para evitar una nueva inundación en esta zona”.
La entrega se llevó a cabo en las calles más afectadas por la inundación, beneficiando a más de 260 casas y más de 1,100 personas de este fraccionamiento.
Cabe resaltar que está es la primera entrega de dos que se llevarán a cabo para apoyar a los vecinos de Rancho San Blas.